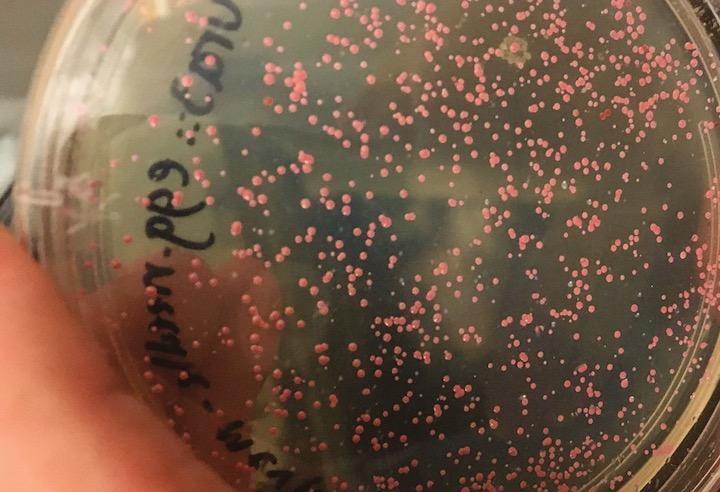

Удалось внедрить цифровые данные в бактериальную ДНК для окончательной капсулы времени
С развитием и широким распространением цифровых технологий объем данных увеличивается. По данным IDC , исследовательской фирмы , специализирующейся в области ИТ, объем данных в мире, который в 2018 году составлял 33 зеттабайта, к 2025 году увеличится более чем в пять раз и достигнет 175 зеттабайт.
Оптические диски, такие как CD и DVD, которые в настоящее время широко используются в качестве носителей записи, легко подвергаются воздействию ультрафиолетовых лучей и влаги, а также подвергаются окислению в зависимости от условий обращения и хранения. Старение неизбежно для флэш-дисков, жестких дисков, магнитных лент и т. д. Поэтому существует движение по изучению потенциала ДНК как носителя, который может хранить записи в течение длительного периода времени.
Сохраненные данные могут быть сохранены почти постоянно, как есть
Джо Дэвису, ученому и художнику из Гарвардского университета в США, удалось внедрить цифровые данные в ген палеонтологической палеонтологии Halobacterium salinalum с высоким содержанием солей, а на 15 февраля 2020 года еще нет. Статья опубликована в репозитории препринтов « Био-Архив ».
Halobacterium salinalum — это тип галофильной бактерии, которая живет в среде с высокой соленостью и устойчива к экстремальным условиям. Биолог Джослин Дильзиелло, адъюнкт-профессор Университета Джона Хопкинса, описала использование halobacterium salinalum в качестве носителя записи в академическом журнале Science как «хорошую идею».
Halobacterium salinalum хорошо устраняет активные формы кислорода, которые повреждают ДНК, и может почти навсегда сохранить данные, хранящиеся в ДНК, восстанавливая окислительные повреждения. Он также перестает расти до тех пор, пока окружающая среда не улучшится, когда питательные вещества будут потеряны, что позволит ему спать в соли в течение тысяч лет с минимальным питанием.
Microsoft также начала использовать молекулы ДНК в качестве устройств хранения данных.
Дэвис закодировал координаты трехмерного изображения яйца и иглы со славянской мифологией «Бессмертный Кощей» как мотив и встроил в геном halobacterium salinalum. Говорят, что модифицированные клетки сохраняли важную информацию даже после самообновления.
В качестве исследовательской деятельности по использованию молекул ДНК в устройствах хранения данных Microsoft также начала в 21 марта 2019 года нам впервые удалось разработать автоматизированную систему хранения и извлечения данных с искусственно созданной ДНК .
